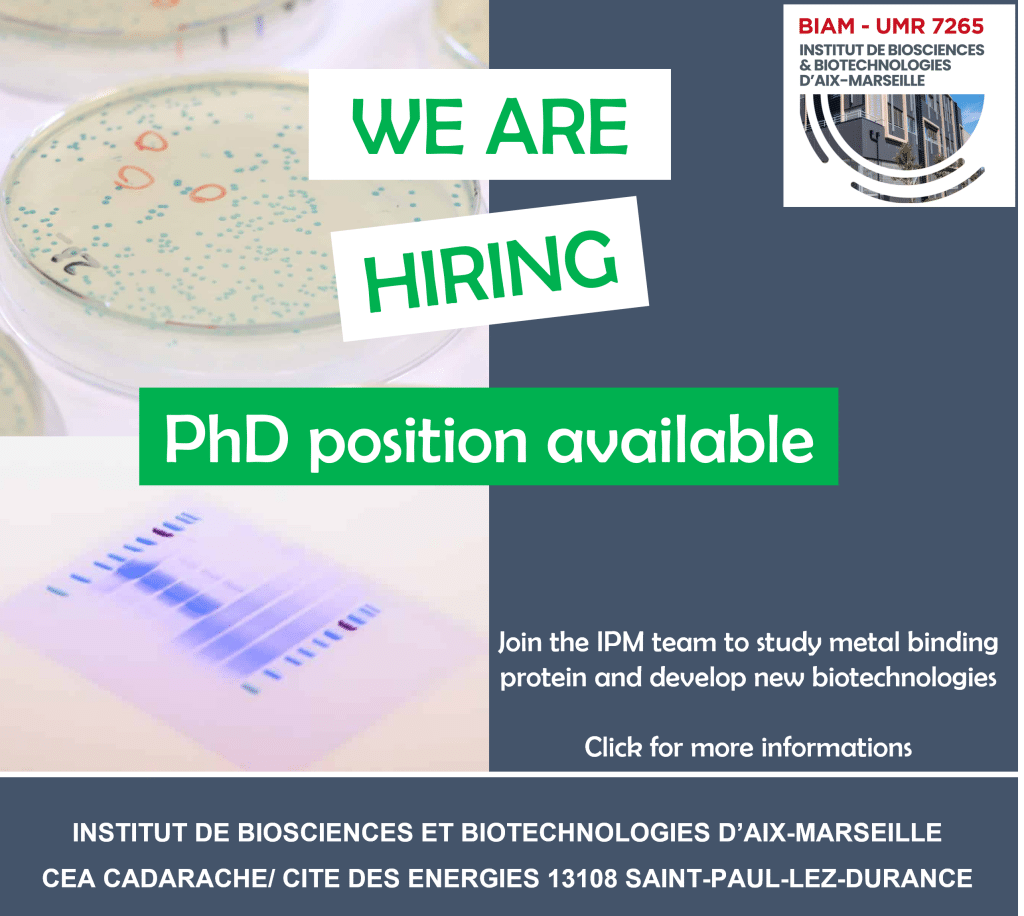

Vous êtes ici : Accueil Cité des Énergies > Emplois
Offres d'emploi
L’Institut de Biosciences et de biotechnologies d’Aix-Marseille (BIAM) recrute des talents scientifiques émergents.
Nous recherchons des scientifiques talentueux dans les domaines des sciences de la vie, de l’adaptation des organismes aux contraintes environnementales, de la bio-ingénierie et de la biotechnologie pour l’énergie et l’environnement.
Vous êtes talentueux et passionné ? Venez partager notre engagement pour un monde plus durable !

Postes à pourvoir :
Postes pourvus :
2025
- Stagiaire BUT
- Chercheur en biochimie des protéines H/F
2024
- Alternance M1 Manager des Ressources Humaines H/F
- Ingénieur en génomique, bioinformatique et écologie évolutive H/F
- Chercheur en physiologie et biochimie des organelles chez les plantes H/F
- Ingénieur d’étude en biologie moléculaire et biochimie H/F
- Chercheur biochimie biophysique des protéines H/F
- Ingénieur d’étude en biochimie moléculaire des plantes H/F
- Technicien supérieur chimie H/F
- Chercheur en Manipulation génétique moléculaire de microalgues ou de cyanobactéries H/F
- Scientit in The crosstalk between the plant and its associated microbiota under drought stress H/F
- Scientit in Improving eukaryotic and/or prokaryotic oxygenic photosynthesis H/F
- Poste demi ATER biologie moléculaire, biochimie et physiologie végétale -campus Luminy H/F